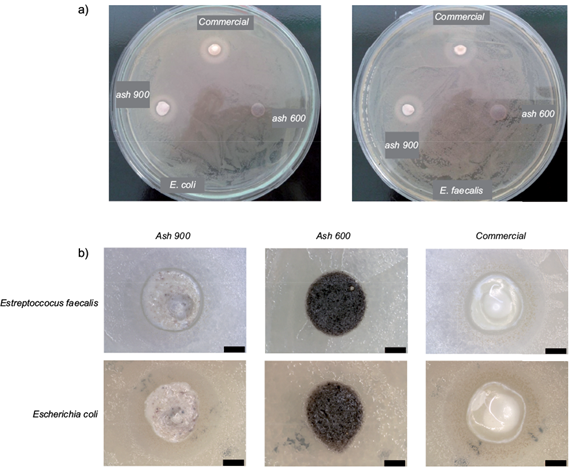

INTRODUCTION
Biomass harvest from semi-arid lands is a very promising source of supplies (Reynolds 2007), leaving cultivable lands focused on food production (Ragauskas et al. 2006). Xerophyte Agavaceae plants like Agave tequilana, are used as source of food, fibers, energy and spirit beverages such as tequila and mescal (Dalton 2005, López-Alvarez et al. 2012). The 300 known Agave species are all native from the American continent where 7500 years ago, agave fibers were used by ancient humans to make footwear (Kuttruff et al. 1998). More recently, the early 90’s witnessed an increase in the popularity of tequila around the world, becoming an attractive industry, not only for Mexican but also for foreign investors. The production of alcoholic beverages from Agave typically follows five steps: cooking, milling, fermenting, distilling and ageing (Martínez-Gutiérrez et al. 2015). As result, every year the tequila industry produces high volumes of bagasse, vinasse and CO2 as byproducts of small economical value (Robles-González et al. 2012). The traditional practices for the management and disposal of bagasse waste, involve sun drying the bagasse, followed by incineration for volume reduction. This produces large quantities of ash with a narrow chemical composition, dependent of the soil mineral composition where the agave is grown, and with potential for further exploitation (Bashan et al. 2006). Addressing this situation, several applications have been developed to take benefit from the agave bagasse, such as fuel (Chávez-Guerrero and Hinojosa 2010), in papermaking (Idarraga et al. 1999), fertilizer or compost (Martínez-Gutiérrez et al. 2013, Rodríguez et al. 2013), and a renewable source of calcium compounds like CaCO3 and Ca(OH)2 (Chávez-Guerrero et al. 2010). In particular, Ca(OH)2 has a wide range of applications. For instance it has been long used as a component in cement (González-López et al. 2015) and more recently as antifungal (Gómez-Ortíz et al. 2013) and bactericidal filling of root canals in endodontic treatment (Gomes et al. 2006) as many other common applications such as food additives and a material source for the production of pulp and steel.
The aim of this work is to provide evidence of the potential use of processed agave biomass waste from the tequila industry as a bactericidal agent against pathogenic bacteria such as Escherichia coli and Enterococcus faecalis. As well as to introduce a renewable source of Ca(OH)2 from agave bagasse, presenting an alternative source of this compound, with the potential to diminish the ecological impact of the tequila industry.
MATERIALS AND METHODS
The agave bagasse was dried at 120 °C for 2 h, then placed into an alumina crucible and heated at 600 °C for 2 h using a Thermolyne furnace to obtain ash, this sample was labeled ash 600. The ash was then heated at 900 °C for 5 h. In the next step, the ash was poured into deionized water and stirred in an ultrasonic bath for 10 min. The samples were left to dry at 100 °C for 5 h, the resulting sample was labeled ash 900. All samples were obtained in triplicate. Analytical grade Ca(OH)2 (Sigma-Aldrich), henceforth identified as commercial, was used as standard to compare the microstructure and bactericidal activity of the analyzed samples. The morphology and composition of the samples were determined using a FEI Scanning electron microscope (SEM) model XL30 with a Schottky field emitter gun (SFEG) with an energy dispersive X-ray microanalysis system and an acceleration voltage of 10 kV. All powders were analyzed by X-ray diffraction (XRD) in a D8 Advance Bruker powder diffractometer. The diffractogram patterns were collected from 2q = 10-60° using a Cu Kα radiation (λ = 1.5406 Å). Raman microspectrometry measurements were recorded at room temperature using a Thermo Scientific DXR Raman microscope with a 532 nm laser excitation. In order to test the compounds efficacy to inhibit microbial growth, an agar diffusion assay was carried on. Two bacteria were tested, Escherichia coli, ATCC 25922 (American Type Culture Collection, Rockville, MD) and Estreptoccocus faecalis, ATCC 29212. E. coli is a Gram-negative, facultative anaerobium, rod shaped bacteria, while E. faecalis is a non-motile, Gram-positive, facultative anaerobic microbe. Assay cultures were prepared by subculture in trypticase soy broth (Merck), culture purity was monitored by microscopy observation. Two hundred µL of culture or a ten-fold dilution were inoculated with a sterile bacterial spreader and smeared in the surface of Muller-Hinton agar plates (Bioxon). Approximately 10 µL of paste, made by mixing each sample with a small volume of water, was placed in equidistant positions in the agar surface. The plates were incubated at 37 °C for 24 h and later examined for inhibition halos surrounding the compounds. All tests were performed in triplicate for each microorganism.
RESULTS AND DISCUSSION
In figure 1 (a), the X-ray results show the main compounds present in the three analyzed samples. For ash 600, the resulting XRD pattern shows the reflection peaks assigned to calcium carbonate (▲). In the case of ash 900, the XRD pattern (Fig. 1c) is associated with the hexagonal crystalline shape of calcium hydroxide.

Fig. 1 Diffractogram patterns of the samples and scanning electron microscope images showing the morphology of (a-b) ash 600, (c-d) ash 900 and (e-f) commercial sample. Scale bar 2 µm. a. u. = arbitrary units
Theoretically, it would be expected for both ash 900 and commercial samples to match the profile available for comparison in the public database (PDF 00-004-0636). However, according to the results, the samples were composed of a combination of calcium hydroxide and calcium carbonate (Fig. 1e). It could be argued that CO2 was adsorbed by the samples during air exposure, resulting in a partial carbonation of the sample. In support of this explanation, a peak observed at 28.5 °C (unexpected for a calcium hydroxide sample) can be attributed to the repeated exposure of the reactive grade powder to the CO2 in the environment, once the container has been opened, producing a partial carbonation of the sample. Equation 1 represents the reaction occurring to CaCO3 (ash) during the heating process. In this process, 56 % (w/w) of the ashes remain as calcium oxide, then by burning 1000 kg of ash approximately 560 kg of CaO could be produced, leaving the total net CO2 emissions unaffected (Chávez-Guerrero et al. 2010).
Equation 2 represents the intermediate exothermic reaction to obtain calcium hydroxide, where lime is mixed with water to obtain Ca(OH)2. The treatment of 560 kg of CaO with water would produce 740 kg of calcium hydroxide. Equation 3 represents the carbonation of calcium hydroxide, which occurs spontaneously in the presence of CO2. Equation 3 thus, represents the behavior exhibited by the ash 900 and commercial sample, which exposure to environmental CO2 produced calcium carbonate, this was also suggested by the XRD results, shown in figure 1.
In figure 1b the original structure of the Agave fibers can still be discerned with small semicircular particles, while in ash 900 hexagonal crystals, characteristic of Ca(OH)2 can be observed (Fig. 1d). In figure 1f the commercial sample shows irregular particle shapes, this might be attributed to the use of grinded limestone during the production process of Ca(OH)2. Even if unexpected, the presence of CaCO3 in the bagasse, can be explained by plant physiology, plants are able to break and solubilize rock by excreting acidic compounds in root exudates (Bashan et al. 2006). This mechanism is used to obtain minerals from poor soils, providing an alternative source of nutrients. As such, this natural occurring mechanism could be exploited for the extraction of several compounds of economic interest, once the biomass has been used in the tequila manufacturing process.
Figure 2 shows the Raman spectra of ash 600 displaying the four characteristic peaks of CaCO3, while for the spectrum of ash 900, besides the expected peaks (Table I), displays an additional peak at 358 cm-1, suggesting the presence of hydrated lime (Tlili et al. 2002, Schotsmans et al. 2014). The Raman spectra of the commercial sample shows identical peaks to those obtained for Ca(OH)2. As it can be observed in the XRD patterns, both ash 900 and commercial samples contain a mixture of Ca(OH)2 and CaCO3, even though the peaks in the Raman spectra are similar in the samples of CaCO3 and Ca(OH)2. The explanation for this peak at 358 cm-1 is the presence of hydrated lime. Calculating the relative intensity (I/Io) of the peak associated to the hydrated lime (358 cm-1), it is possible to study the carbonation of Ca(OH)2 samples as shown in table I.

Fig. 2 Raman spectra of the three samples studied. The arrow indicates the peak at 358 cm-1. a.u. = arbitrary units
Table I Vibrational wavenumber (cm-1), intensities in arbitrary units and relative intensity (%), with dispersive Raman spectroscopy at 532 nm excitation

W = wavenumber I/Io = relative intensity I = intensity
Table I shows the relative intensity (I/Io) of the analysis, where both commercial sample and ash 900 exhibit the 358 cm-1 peak. It can be seen that the relative intensity is 12.7 % (I/Io=(398.7/3139.1)×100) for the commercial sample and 20.7 % (I/Io=(339.6/2371.0)×100) for ash 900, indicating a lower carbonation of the sample obtained from the agave bagasse (Schotsmans et al. 2014), something that can be corroborated by the XRD results and SEM images shown in figure 1. These differences in the carbonation degree between ash 900 and commercial sample might be attributed to a longer exposure of Ca(OH)2 to the environment, unlike ash 900, synthetized from CaO just a few hours before all the tests were performed. These observations suggest that Ca(OH)2 must be synthesized just before its application as bactericidal agent for maximum efficacy, thus avoiding the creation of CaCO3, which lacks antibacterial properties.
For the agar diffusion assay, after a 24 h incubation, E. coli and E. faecalis were observed covering the agar plate surface, displaying inhibition halos surrounding both samples of Ca(OH)2 ash 900 and commercial sample, while no effect was observed for calcium carbonate (ash 600), as it can be seen in figure 3a-b. In figure 3b, an amplification of the inhibition halo is presented. For E. faecalis, the width of the halo is about the same for commercial sample (1.7 mm) and ash 900 (2.1 mm), respectively. The ash 600 sample did not show an effect on bacterial growth, excluding the possibility of an inherent bactericidal activity of unprocessed ash.
Fig. 3 a) Agar diffusion assay showing inhibition halos surrounding ash 900 and commercial sample, b) Halos seen under the optical microscope at 8x. Scale bar 2 mm
In the case of E. coli, the inhibition halo width is very similar for ash 900 (1.9 mm) and commercial sample (2.1 mm). Nevertheless, halo size is not the main factor to consider for most of the potential applications, since the putative mechanisms for Ca(OH)2 bactericidal activity are contact-mediated.
CONCLUSIONS
The successful synthesis of calcium hydroxide using bagasse produced by the tequila industry was demonstrated by the XRD and the Raman spectroscopy analysis. According to the results, it can be concluded that Ca(OH)2 obtained by the thermochemical transformation of Agave bagasse harvested from semi-arid lands, exhibits antimicrobial activity against E. coli and E. faecalis, two pathogenic microorganisms of relevance. The synthesis of Ca(OH)2 from Agave bagasse and its antimicrobial activity provide evidence to support the continuous use of industrial byproducts.
Most importantly, biomass from Agave is abundantly available in Mexico, and the use of processed bagasse for medical applications could provide a venue for the useful disposition of industrial waste with an added value to the environment. Future work will focus on determining the extent of the bactericidal properties of Ca(OH)2 obtained from Agave bagasse. These properties will be tested against commercial Ca(OH)2, over longer periods of time and a battery of several pathogenic bacteria using solid and liquid media.











 nueva página del texto (beta)
nueva página del texto (beta)





